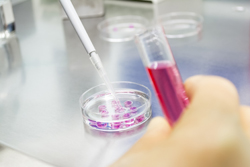

Novel biosensors for sensitive diagnosis
Environmental monitoring and various life science applications require devices capable of detecting the levels of certain biomolecules or other compounds. The unique properties of nanomaterials – substances manufactured at an extremely small scale – offer excellent prospects for the construction of bioelectronic sensors.The EU-funded ′Multifunctional Organic-inorganic Elements with Biosensing re-Usability′ (MOEBIUS) study aimed to generate novel reusable biosensors capable of detecting important diagnostic biomarkers. To this end, scientists used semiconductor nanostructures as an interface between conventional electronics and bio-active sensor compounds. Metal oxide surfaces were used to immobilise various enzymes as a means of multiplying the response of the device by many orders of magnitude. These nanopore-embedded enzymes exhibited great stability and allowed for sequential enzymatic analysis to be conducted. Additionally, the generated sensors showed great sensitivity in detecting bile acid and adenosine deaminase levels down to the micromolar range. On top of that, the sensors were simple to use and re-usable. The obtained structures were already tested in the diagnosis of liver diseases in a prototype bio-diagnostics instrument. The applicability of the sensor could also be adapted for detection of other diseases and toxins with high accuracy and reliability.